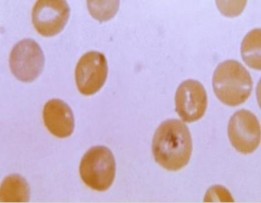
1 2 Môi trường lỏng I Ống số 1 là chứng âm và mẫu nghiên cứu ống số 2 7

5’TTCAACTGTCTGGAATGG-3'; JEV- E-p2: 5’AGCATGCACATTGGTAGCT-
A-3 'with the program: 50°C for30 minutes, 95°C for15 minutes; 30 cycles (94°C for 1 minute, 50°C for
1 minute, 72° C for 1 minute), 72°C for10minutes, hold at 4oC. PCR products were tested on the 1% agarose gel. The band containing the PCR product is eluted and purified using the QIAquick PCR Purification Kit (Qiagen) for sequencing. Gene sequencing was performed with Applied Biosystems™ Sanger Sequencing Kit (Thermo Fisher Scientific) and ABI 3500 gene sequencing machine of the Institute of Biotechnology, Vietnam Academy of Science and Technology. E gene sequences were analyzed using available software on the internet such as Blast, BioEdit, MEGA6.0 to evaluate the similarity and build phylogenetic trees based on regional sequence E gene of 2 strains Beijing-1 with standard strain and JEV strains isolated from humans, pigs, and mosquitoes in Vietnam from 1964 to 2014 (Table 1). Analysis of E region antigen epitopes was conducted according to the method of Luca et al. (2012).
RESULTS
Results of E gene amplification of master seed, working seed, and reference strains
The gene encoding the E antigen of the master seed strain BV-MSV-0210, working seed strain BV-WSV-0310 and the reference standard strain of JEV
Beijing-Kanonji were amplified by RT- PCR. The results showed that the PCR product is very specific, without byproducts, the size is equivalent to the length of E gene according to theoretical calculations (about1500
bp).Results are shown in Figure 1.
M 1 2 3
1500 bp-
1000 bp-
Figure 1. Agarose gel 1% electrophoresis for testing RT-PCR products amplified gene encoding E antigens of strains: original strain BV -MSV-0210 ( lane No. 1); production strain BV-WSV-0310 (lane No. 2); Standard strain reference original JEV Beijing-Kanonji (lane No. 3). M: Farmentas 1 kb DNA ladder.
Resultsof sequencingand analysisof genes encoding E antigens of master seed
and working seed strains
PCR products were collected by gel eluted method, purified by QIAquick PCR Purification Kit, and sequenced by ABI 3500 gene sequencing machine. After sequencing, we used specialized software programs such as Blast, BioEdit, MEGA6.0 ... to analyze, evaluate the similarity and build phylogenetic trees based on
the E region sequence of the master seed BV-
MSV-0210and working seed BV- WSV0310strains. The results showed that the gene encoding E antigen has a length of 1500 bp, a G/C ratio of 52%, which encodes a protein with a length of 500 amino acids.
The length and nucleotide and protein sequences of the gene coding for E- antigen the MSV, WSV and reference strain are completely identical. These strains have 100% similarity for both nucleotides and amino acids. However, when comparing the nucleotode and amino acid sequences of the seed strains with the gene sequences encoding E antigens of JEV strains isolated in Vietnam, the similarity percentage is very different (Table 1).
Based on the results of comparing the nucleotide and protein sequences of the gene coding for E antigen of MSV and WSV strains compared with the reference strain (BeijingKanonji) and the JEV strains isolated in Vietnam from 1964 to 2014, we created a phylogenetic tree to evaluate the nucleotide and protein
correlation between strains studied (Figures 2 and 3).
The results determined the epitope positions of protein E of the WSV and MSV strains
Comparing nucleotide sequence and E gene protein of the WSV strain and MSV strain with JEV strains isolated in Vietnam, especially strains isolated from human, the results show that this rate ranged from 86.67 to 97.53% for
nucleotides and 96.73 to 99.00% for proteins. We have examined whether the epitopes crucial to the immune response for neutralized antibodies change or not. Using the method of Luca et al. (2012), we determined the positions of the epitopes and the positions of amino acids that determine the epitope for antigenic properties. The results are shown in Table 2.
As results, (Table 2) the amino acids of the epitopes of the gene encoding the E antigen in the WSV strain, the reference strain, the SA1414-2 vaccine strain, and the JEV strain isolated from humans in Vietnam in 2014 did not change.
Table 1. Nucleotide and protein sequence similarity ratio of E antigen-encoding gene of master seed strain (BVMSV-0210) and working seed strain (BV-WSV-0310) compared to E-gene sequence of JEV strainsisolated in Vietnam over different years and from different hosts.
Nucleotide and protein sequence No. Accession in Years of Hosts similarity ratio (%)
GenBank | isolation | Nucleotide | Protein | ||
1 | LC000631 | 1964 | Human | 97.45 | 98.31 |
2 | AY376461 | 1986 | Human | 96.40 | 99.00 |
3 | AY376463 | 1989 | Human | 96.73 | 99.20 |
Có thể bạn quan tâm!
-
P. Wijesinghe (2012), Japanese Encephalitis : A Manual For Medical Officers. -
So Sánh Trình Tự Nucleotide Của 03 Chủng (Chủng Giống Gốc Bv-Msv-021, Bv-Wsv- 031 Và Chủng Tham Chiếu Beijing-Kanonji) -
Kết Quả Giải Trình Tự Acid Amin Protein E Chủng Giống Gốc Bv-Msv-0210 Và Chủng Giống Sản Xuất Bv-Wsv-0310 -
Kiểm Tra Virus Ngoại Lai Trên Tế Bào Chứng Trong Sản Xuất Vắc Xin/sản Xuất Chủng -
Kiểm Tra Virus Ngoại Lai Trong Ngân Hàng Tế Bào (Mcb, Wcb) -
Nghiên cứu xây dựng tiêu chuẩn chất lượng vi rút Beijing-1 để ứng dụng sản xuất vắc xin viêm não Nhật Bản bất hoạt trên tế bào Vero tại Việt Nam - 21
Xem toàn bộ 178 trang tài liệu này.
HQ009263 | 2004 | Human | 97.53 | 97.20 | |
5 | LC000634 | 2007 | Human | 87.45 | 96.73 |
6 | KP876007 | 2014 | Human | 86.67 | 97.04 |
7 | AY376464 | 2001 | Pig | 88.33 | 98.40 |
8 | AY376465 | 2002 | Pig | 88.27 | 98.40 |
9 | HQ009265 | 2005 | Pig | 87.47 | 98.00 |
10 | JEU70420 | 1979 | Mosquito | 99.00 | 98.06 |
11 | AB933311 | 1994 | Mosquito | 88.05 | 98.22 |
12 | AY376468 | 2002 | Mosquito | 88.33 | 98.40 |
13 | JN574431 | 2005 | Mosquito | 87.80 | 98.04 |
14 | LC000635 | 2010 | Mosquito | 87.54 | 96.77 |
15 | LC000637 | 2011 | Mosquito | 86.05 | 94.55 |

Figure 2. Phylogenetic tree based on E gene nucleotide sequence of the WSV strain (BV-WSV-0310), MSV (BV-MSV-0210), original reference strain (Beijing-Kanoji), and the JEV strains isolated in Vietnam from 1964 to 2014.

Figure 3. Phylogenetic
tree based on E gene
protein sequence of
the WSV strain (BV-
WSV-0310), MSV
(BVMSV- 0210),
original reference
strain (Beijing-
Kanoji), and the JEV
strains isolated in
Vietnam from 1964 to
2014.
Table 2. Position of
epitopes and positions of
amino acids determining
antigens of epitope on
protein E of the WSV
strain (BV- WSV-3010),
reference strain
(Beijing- Kanonji),
JEV strain isolated in
humans 2014 and
vaccine strain SA14-
14-2.
Domain II-fusion
Position ofneutralizing
loopprotein E
Domain I-IIhinge
Side
chains of Domain I
Side chains of Domain III
106 | 107 | 52 | 126 | 136 | 275 | 179 | 337 | 360 | 302 | 387 | |
14-2 (Luca et al.) G AA of the strain BV- | G | L | Q | I | K | S | K | I | F | G | R |
WSV-3010 G AA of the strain | G | L | Q | I | K | S | K | I | F | G | R |
2014 _KP876007_Human | |||||||||||
_ProE G | G | L | Q | I | K | S | K | I | F | G | R |
AA of the strain Kanonji G | G | L | Q | I | K | S | K | I | F | G | R |
DISCUSSION
Japanese Encephalitis virus (JEV) is the leading cause of viral encephalitis globally. The envelope protein of the JEV (protein E) facilitates virus binding on the cell surface and membrane fusion, which
is the primary target of antibodies that neutralize the virus (Luca et al., 2012). Therefore, the efficacy of JE vaccine depends on the ability to produce antibodies to neutralize E protein. Since 2006, inactivated Japanese encephalitis vaccine has been researched and produced by Vabiotech company from Beịing-1 on Vero cell. The results of clinical trials on humans showed that the vaccine was safe and created 100% protective antibodies after the booster injection. To officially put this vaccine into production and mass use, the evaluation of genetic stability and E- antigens similarity of the WSV strain and MSV strain compared with the JEV strains circulating in Vietnam are essential. The gene encoding the E antigen of the seed lots includes the Master Seed Bank BV-MSV-0210 and the Working Seed Bank BV-WSV-0310 with the reference standard strain JEV Beijing-Kanonji were sequenced and analyzed for similarity. The results showed that 2 batches of WSV have the similarity of amino acids and nucleotides of 100% compared with the reference strains. Thus, it can be concluded that the MSV strain and the WSV strain have genetic stability. However, the question that needs to be answered is, do the strains used in production have similar antigens to neutralizing antibodies against JEV strains circulating in Vietnam? To answer this question, the E gene region nucleotide sequences of the two strains were compared with the E gene region sequences of JEV strains isolated from humans, pigs and mosquitoes in Vietnam
and submitted in GenBank from 1964 to 2014 (Table 1). The results showed that, the similarity of the nucleotide of the strain compared with the strains VNNB isolated from humans ranged from 86.67 to 97.54%; from pigs is 87.47 to 88.33% and from mosquitoes is 86.05 to 99%.Meanwhile, the amino acid similarity of the strain compared to the strains of JEV isolated from human ranged from 96.73 to 99.02%; from pigs is 98.00– 98.40% and from mosquitoes
94.55 to 98.40%. Looking closely at the variation of the nucleotide sequence as well as the protein sequence of the JEV strains in Table 1, we can see that the similarity level decreases over time. For example, the nucleotide similarity of JEV isolated from humans in 1989 was 96.73% and protein was 99.20, by 2014 this similarity level was only 86.67% for nucleotides and 97.04. % for protein. So, is it because the pressure when using JE vaccine since 1990 has created mutant strains to gradually evade the protective ability of the vaccine? According to Roy el al. (2020), when the structure of the neutralizing antibody epitopes changes, the JEV can evade the protective ability of the neutralizing antibody produced by vaccines.To be able to elucidate this problem, we have used the method of Luca et al. (2012) to compare the amino acid sequence in the neutralizing antibody epitope region of Domain I, II and III of MSV strain, WSV strain and reference strain with JEV strains circulating in human isolates in 2014. Results showed that, no change of amino acids determining the configuration of antigens
belonging to these epitopesfound (Table 2). That partly explains that vaccines produced by the WSV strains derived from the MSV strains still create 100% protective antibodies. According toDo Tuan Datet al. (2017), the JECEVAX vaccine produced from the MSL BV- MSV-0210 and the WSL BV-WSV-0310
was safe and hadeffective protection100%after the third injection. The titer of antibodies to neutralize GMT using the PRNT method increased after 2 doses of 2.09 logs and 3.04 logs after 3 doses.This result is equivalent to the vaccine of the same type of Japan (CCJEV) and the Republic of Austria (IXIARO).The protective effect of this vaccine was even better than that of the control group using the JEVAX vaccine (the vaccine being used in the expanded vaccination program in Vietnam, produced on mouse brain with Nakayama strain) only reached 99%. Some other vaccines currently circulating in Vietnam are Imojev (live chimeric vaccine, strain SA14-14-2, produced by France) or JEEV vaccine (made in India) also has a protective effect of 95–98%.
CONCLUSION
With the results obtained above, it can be confirmed that 2 lots of Beijing-1strains (BVMSV-0210 and BV-WSV-0310)
produced by Vabiotech company have high genetic stability with standard strains. The nucleotide sequence similarity of the gene encoding E antigen of the WSV strain compared to the JEV strains circulating in Vietnam from 1964 to 2014 is from
86.67 to 97.54% in humans; 87.47– 88.33% in pigs and 86.05–99% in mosquitoes. Meanwhile, the amino acid similarity of the WSV strain compared to the strains of JEV isolated from human ranged from 96.73 to 99.02%; from pigs is 98.00-98.40% and from mosquitoes
94.55 to 98.40%. When comparing the amino acid sequence in the neutralizing antibodyepitopes of the WSV strain and the MSV strains with the JEV strain circulating in humans in 2014, there was no change of amino acids that determine the conformation of the antigen. REFERENCES
Do Tuan Dat, Vu Dinh Them, Tong Thien Anh, Nguyen Thi Ly (2017) Safety and immunogenicity of Japanese encephalitis vaccine produced on Vero cells (JECEVAX) in children (stage II)”. J Prevent Med 27(6): 53-61.
European Pharmacy, 2017. Page 1508-1509.
Huynh Phuong Lien, Nguyen Anh Tuan, Tran Hang Nga, Nguyen Que Anh et al. (2011) Research and development of Japanese Encephalitis inactivated vaccine on vero cells. J Prevent Med 4(103), 2009: 86- 91.
Luca VC, AbiMansour J, Nelson CA, Fremont DH (2012) Crystal Structure of the Japanese Encephalitis Virus Envelope Protein. J Virol 86: 2337–2346.
Nguyen Thi Ly, Huynh Phuong Lien, Do Tuan Dat, Doan HuuThien, Pham Van Hung, Nguyen Thi Mai Huong (2018) Quality of Japanese encephalitis inactivated vaccine produced on Vero cells in Vietnam. National Biotechnology Conference 2018, October 26, 2018. Natural Science and Technology Publishing House, 2018, page 512.
Roy U (2020) Structural and molecular analyses of functional epitopes and escape mutants in Japanese encephalitis virus envelope protein domain III. Immunol Res 22: 1–9.
Sharma P, Mittal V, Chhabra M, Singh P, Chauhan LS, Rai A (2014) An Update on JE Vaccine Development and Use. J Commun Dis 46: 109–118. WHO TRS No. 963, (2007) Annex 1.
Recommendations for Japanese encephalitis vaccine (inactivated) for human use.
ĐÁNH GIÁ SỰ TƯƠNG ĐỒNG VỀ GEN VÀ PROTEIN CỦA CHỦNG SẢN XUẤT VACCINE BEIJING-1 SO VỚI CÁC CHỦNG VIRUS VIÊM NÃO NHẬT BẢN ĐANG
LƯU HÀNH TẠI VIỆT NAM
NguyễnThị Lý1, Huỳnh Thị Phương Liên2, ĐỗTuấn Đạt2, Nguyễn Kim Bách1, Nguyễn Hoàng
Tùng1, Hà Thị Thu1, Đinh Duy Kháng3
1Viện Kiểm định Quốc gia Vắc xin và sinh phẩm y tế (NICVB)
2Công ty TNHH MTV vắc xin và sinh phẩm số 1 (VABIOTECH)
người, lợn và muỗi ở Việt Nam. Kết quả cho thấy, sự tương đồng về nucleotide của chủng giống so với các chủng virus VNNB phân lập từ người dao động từ 86,67 đến 97,54%; từ lợn là 87,47 đến 88,33% và từ muỗi là 86,05 đến 99%. Trong khi đó, sự tương đồng về amino acid của chủng giống so với các chủng virus VNNB phân lập từ người dao động từ 96,73 đến 99,02%; từ lợn là 98,0098,40% và từ muỗi là 94,55 đến 98,40%. Trình tự amino acid trong vùng epitope sinh kháng thể trung hòa của chủng giống không có sự khác biệt so với chủng virus VNNB lưu hành trên người phân lập năm 2014.
Từ khóa: Chủng Beijing-1, Chủng giống gốc, chủng giống sản xuất, gen mã hóa kháng nguyên E, sự tương đồng nucleotide, sự tương đồng amino acid, epitope sinh kháng thể trung hòa.
1 Viện Công nghệ sinh học (IBT), Viện Hàn Lâm KH&CN Việt Nam (VAST)
TÓM TẮT
Từ năm 2006, vaccine viêm não Nhật Bản bất hoạt đã được nghiên cứu sản xuất bởi công ty VABIOTECH từ chủng Beịing-1 trên tế bào Vero. Vaccine sản xuất từ các lô chủng giống gốc và giống sản xuất đã được đánh giá ở quy mô phòng thí nghiệm và quy mô lâm sàng trên người. Kết quả cho thấy, vaccineđạt an toàn và tạo kháng thể bảo vệ 100% sau mũi tăng cường. Để chính thức đưa vắc xin này vào sản xuất và sử dụng đại trà, các lô chủng giống gồm chủng giống gốc BV-MSV-0210 và chủng giống sản xuất BV-WSV-0310 cùng chủng chuẩn tham chiếu JEV Beijing-Kanonji do Nhật Bản cung cấp đã được kiểm tra về tính ổn định di truyền. Bằng phương pháp giải trình tự Sanger và phân tích gen với các chương trình phần mềm khác nhau, chúng tôi đã đánh giá sự tương đồng về trình tự nucleotde và protein của gen mã hóa kháng nguyên E. Kết quả cho thấy, 2 lô chủng giống có sự tương đồng về amino acid và nucleotide là 100% so với chủng tham chiếu. Như vậy, có thể kết luận, chủng giống gốc và chủng giống sản xuất có tính ổn định về kháng nguyên. Trình tự nucleotide và amino acid vùng gen E của 2 lô chủng giống đã được so sánh với các chủng virus phân lập từ
Phụ lục 3. Một số hình ảnh kết quả thí nghiệm trong nghiên cứu
| |
Chủng virút Beijing-1 BV-MSV-0210 | Chủng virút Beijing-1 BV-WSV-0310 |
|
| |
1 2 Môi trường lỏng I: Ống số 1 là chứng âm (và mẫu nghiên cứu); ống số 2 là chứng dương khi có Mycoplasma | 1 2 Môi trường lỏng II: Ống số 1 là chứng âm (và mẫu nghiên cứu); ống số 2 là chứng dương khi có Mycoplasma | Hình ảnh Mycoplasma trên môi trường đặc |